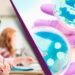
Urge tomar medidas para prevenir las infecciones asociadas a la atención de la salud en México

“No hay mucho por hacer” es una frase común que actualmente suelen escuchar los pacientes al saber que desarrollan Fibrosis Pulmonar Progresiva (FPP), grave condición que, ante la ausencia de tratamientos específicos para su control, condena a quienes la padecen a vivir dependientes de oxígeno en todo momento, con la sentencia de deterioro de la función pulmonar y sus fatales consecuencias.
Hoy la Fibrosis Pulmonar Progresiva deja de ser una “sentencia de muerte” con la reciente aprobación de la nueva indicación de la molécula de Boehringer Ingelheim para el tratamiento de las enfermedades pulmonares intersticiales con FPP, por parte de la Comisión Federal para la Protección contra Riesgos Sanitarios (COFEPRIS), convirtiéndola en la primera terapia en México recomendada por los expertos para mejorar la salud de los pacientes que actualmente presentan esta condición.
La Fibrosis Pulmonar Progresiva puede desarrollarse durante el curso de la enfermedad pulmonar intersticial[1], se identificará cuando ocurren dos de las siguientes manifestaciones: deterioro de los síntomas respiratorios, empeoramiento de las pruebas de función pulmonar (espirometría y difusión de monóxido de carbono) e incremento de las cicatrices en la tomografía de tórax,5 ocasionando dificultad para respirar y afectación de órganos por el deficiente suministro de oxígeno[2], explicó la Dra. Ivette Buendía, Responsable del Laboratorio de Investigación en Envejecimiento y Fibrosis Pulmonar del Instituto Nacional de Enfermedades Respiratorias (INER).
“La nueva indicación para esta molécula viene a cambiar el curso del tratamiento de la Fibrosis Pulmonar Progresiva, al contar con una terapia especifica que, al administrarse oportunamente, en algunos pacientes disminuye el declive de la función pulmonar y reduce la progresión de la fibrosis, transformado así la vida de los pacientes y sus familias”, destacó la Dra. Isabel Balderas, Gerente Médico del área de Alta Especialidad para Boehringer Ingelheim México, Centroamérica y el Caribe.
“Quienes padecen enfermedades pulmonares intersticiales requieren visitas médicas seriadas con su neumólogo para identificar oportunamente el incremento en la frecuencia de la tos y falta de aire, pérdida de función pulmonar y aumento de la cicatrización (fibrosis) para identificar la condición de Fibrosis Pulmonar Progresiva y ajustar el tratamiento a tiempo”[3], mencionó la Dra. Ivette Buendía.
“Si bien en nuestro país no se conoce la cifra exacta de la prevalencia de esta condición, padecimientos asociados como la artritis reumatoide y esclerosis sistémica tienen una alta incidencia en el mundo, de las cuales se estima que aproximadamente entre el 40 y 50% presentarán fibrosis pulmonar progresiva en algún momento de su evolución.5 Esta situación resalta la necesidad de contar con un sistema de salud atento a la identificación y atención oportuna de esta mortal condición en México”, enfatizó.
Por su parte, el Dr. Omar Barreto, especialista en enfermedades pulmonares intersticiales, destacó que “antes de la llegada de esta nueva indicación del antifibrótico, los pacientes que presentaban alguna enfermedad intersticial asociada a esclerosis sistémica o artritis reumatoide, entre otras, tenían una menor esperanza de vida a pesar de contar con un tratamiento para la misma. Hoy, gracias a la disponibilidad de una terapia dirigida a la Fibrosis Pulmonar Progresiva, es posible enlentecer la progresión de los síntomas y, por lo tanto, mejorar los años de sobrevida de los pacientes.”
El también neumólogo y Coordinador de Atención Médica en el INER, señaló que nintedanib es un antifibrótico que inhibe los procesos involucrados en la progresión de la fibrosis pulmonar, el cual ha demostrado en ensayos clínicos internacionales una reducción estadísticamente significativa en la progresión de la FPP, haciendo más eficaz la función pulmonar y previniendo el riesgo de episodios de exacerbación aguda de los síntomas, lo que se traduce en una disminución de discapacidad y muerte[4].
“Contar con un tratamiento específico para la Fibrosis Pulmonar Progresiva es toda una revolución para la vida de los pacientes al permitirles realizar actividades anteriormente impensables, como poder vestirse o caminar diez metros de una habitación a otra sin necesidad de oxígeno, o reducir sensiblemente el número de ingresos al hospital por una menor presencia de exacerbaciones propias de la enfermedad.”, dijo el Dr. Barreto.
Durante su intervención la Dra. Isabel Balderas expresó: “en Boehringer Ingelheim nos sentimos orgullosos de poder contribuir a que los pacientes cuenten con el primer tratamiento en el mundo que ha demostrado ser seguro y eficaz para retrasar la progresión de la fibrosis pulmonar progresiva y, con ello, mejorar la calidad de vida y esperanza a quienes desarrollan esta condición, dando respuesta a una necesidad médica insatisfecha donde hasta ahora no existía una opción terapéutica”.
Junto con la aprobación de la COFEPRIS, a esta nueva indicación se suman las recientes aprobaciones por parte de la Agencia Europea de Medicamentos (EMA) y la Administración de Alimentos y Medicamentos (FDA) de Estados Unidos, entre otras instancias sanitarias en el mundo.